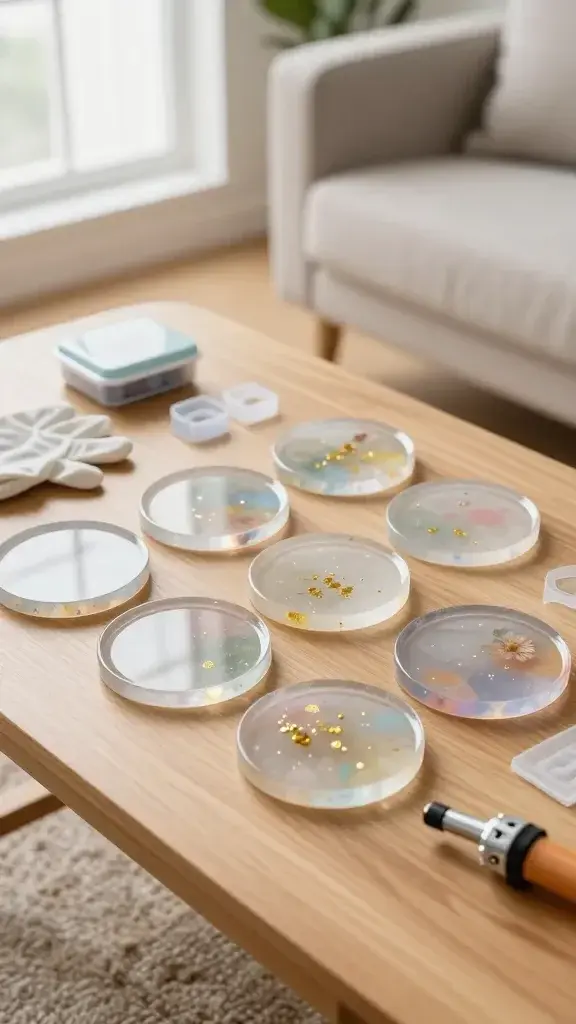
A high-resolution, realistic photo of a set of polished resin coasters arranged on a light wooden coffee table in a bright, cozy living room. The coasters are clear and glassy with subtle, colorful inclusions (tiny gold flakes, pastel pigments, and a couple with delicate embedded flowers) that catch the soft natural light from a nearby window. Show a small resin kit box, a few molds, and a protective glove resting nearby to imply beginner-friendly steps, along with a mini butane torch slightly outside the frame to suggest bubble removal. Include a neatly folded cloth and a faint background blur of a stylish sofa and plant, with a clean, modern aesthetic and a shallow depth of field focusing on the glossy surface and reflections of the coasters. No text on the image.

25 Hobbies and Crafts to Try When You Feel Stuck
Stuck in a rut? These creative hobbies and crafts are all about quick wins, big smiles, and tiny masterpieces you can finish in a single afternoon. Let’s jump in and find your new favorite obsession without the overwhelm.
1. Layer Textures Like a Pro

Texture makes any space feel alive and any project feel finished. Start mixing fabrics, papers, and small trinkets for a tactile payoff you can see and touch.
Key Points
- Gather scraps: burlap, velvet, denim, and cotton
- Use a comfy palette to keep things cohesive
- Add a stitched or fringe element for depth
End result: a tactile, cozy vibe you’ll want to touch again and again. Perfect for quick room refreshes or journal covers.
2. Watercolor Postcards on a Whim
A splash of color can reset your mood in minutes. Watercolor postcards are inexpensive, portable, and surprisingly forgiving for beginners.
Tips
- Choose soft washes and simple motifs
- Let each card dry before moving to the next
- Seal with a spray fixative for longevity
Bonus: you can mail them, gift them, or pin them on a board for daily inspiration.
3. Upcycle Old Teen Fashion into Jewelry
Say goodbye to waste and hello to wearable art. Transform broken bracelets, buttons, or thrift-store bits into bold pieces.
What to Use
- Jump rings, pliers, and wire
- Chunky beads and vintage charms
- Small clasps and cord for variety
Wearable art that tells your story—seriously satisfying to make and wear.
4. Miniature Cloud Ornaments for Your Desk
These tiny, fluffy clouds bring whimsy to your workspace. They’re cute, quick, and oddly calming to craft.
How to Create
- Materials: polymer clay, cotton batting, paint
- Bake, shade, and seal for a lasting finish
End with a string for hanging or a tiny stand—your choice. Colleagues will ask where you bought them.
5. Doodle Banner Wall Art
Turn your doodles into a one-day wall piece. It’s less pressure than a full mural and endlessly customizable.
Process
- Sketch a simple phrase or motif
- Pin or tape on a corkboard or canvas
- Seal with a matte finish for longevity
Bonus: swap out sections as your mood changes. Trust me, it stays fresh.
6. Ferment Tiny Batches of Miso or Kimchi
Foodie alert: fermentation is oddly magical and surprisingly forgiving. A small jar teaches patience, science, and flavor. Do not do this without following a recipe or the product may spoil.
What You’ll Do
- Clean jars, label dates, and keep a simple log
- Adjust salt and temperature to taste
- Taste weekly and note changes
End result: tangy, probiotic goodness with zero guilt about trying something new.
7. Calligraphy for Everyday Joy
Dial back the noise with graceful letters. You’ll love the meditative rhythm of shaping each stroke.
Key Elements
- Quality nib and ink or brush pens
- Warm-up drills and simple alphabets
- Practice sheets for consistency
Use your new skill on cards, journals, or gift wrap—small wins that feel luxe.
8. Build a Tiny Indoor Garden Box
Green therapy in a compact form. A small garden box brightens any room and teaches care and patience.
What to Plant
- Herbs like basil or thyme
- Compact greens such as lettuce or arugula
- Colorful edible flowers for flair
Bonus: it’s a living reminder to slow down and enjoy watching things grow.
9. Paper Craft: Origami with a Modern Twist
Origami isn’t just folded paper; it’s a tiny exercise in focus and creativity. Keep a folder of folds you love.
Starter Folds
- Crane, heart, and bookmark shapes
- Use sturdy paper for crisp folds
- Decorate with washi tape for a contemporary look
End note: fold these during calls or commutes for a calm, productive break.
10. DIY Soap or Bath Bomb Studio
Self-care becomes a craft project you can actually finish. Craft scents, colors, and textures to suit your vibe.

Materials to Gather
- Base soap or bomb molds
- Natural colorants and essential oils
- Simple additives like dried petals or oats
Hint: package them nicely and you’ve got thoughtful gifts ready in a snap.
11. Scrapbook Your Year in 30 Minutes a Night
Past memories deserve a tidy home. A quick scrapbook session keeps momentum without turning into a project mountain.
Layout Tips
- One page per month or event
- Include tiny captions and stickers for personality
- Use a simple color scheme for cohesion
Result: a tangible memory stash you’ll flip through with a grin.
12. Crochet a Quick Cozy Blanket
Nothing says “I did something cozy” like a handmade blanket. Choose a forgiving stitch and chunky yarn for speed.
Why It Works
- Immediate visual progress
- Chunky yarn = fewer rows to finish
- Great for binge-watching sessions
Wrap yourself or a friend in warmth and pride.
13. Sketch a Daily Object a Week Challenge
Sketching daily sharpens your eye and reduces anxiety about perfection. Start with simple objects and build.
Structure
- One object per day, 15–20 minutes
- Use a no-press mindset; keep it playful
Benefits: better observation, faster drawing, more confidence in your own style.
14. Resin Coasters: Clear, Glassy Wins
Resin coasters that look pro but are beginner-friendly. It’s a small project with big bragging rights.
What You’ll Need
- Resin kit, molds, and protective gear
- Color pigments or small inclusions
- Heat gun or torch to remove bubbles
End use: daily joy on your coffee table, or a chic gift idea.
15. Zen Sand Practice Mini-Terrariums
Calm in a glass: yin to your chaotic week. A tiny beach of sand and mini rakes is oddly soothing.
Components
- Clear glass container
- Colored sand, gravel, and tiny figurines
- Fine spoon for layering
Use as a mindful break during workdays or a desk centerpiece.
16. Embroidery Hoop Wall Decor
Thread sculpted art that’s modern and family-friendly. Start with a simple motif and go from there.
What to Stitch
- Geometric patterns or botanical leaves
- Color in bold or keep it monochrome
Benefits: portable craft that upgrades your walls in under an afternoon.
17. Homemade Spice Mixes and Rubs
Cooking meets crafting in your own personalized flavor folder. It’s practical, tasty, and surprisingly fun to mix and label.
Starter Combos
- Smoky paprika blend
- Herb classic rub
- Sweet chili mix
Use these for grilling, roasting, or a quick flavor boost on weeknights.
18. Terracotta Pot Paint Party
Give boring pots a personality overhaul. It’s a quick paint-splash that makes your green friends smile back at you.
Pro Tips
- Seal with acrylic varnish for durability
- Use painter’s tape to create clean lines
Result: vibrant pots that double as tiny canvases for your plant squad.
19. DIY Candle Making in a Snap
Ambiance in a jar. Candle making is cozy, aromatic, and adaptable to any season.

Basics
- Beeswax or soy wax, wicks, and fragrance oils
- Color chips for mood-matching jars
You’ll probably want a waterproof surface and a quiet afternoon for melting and pouring.
- 🧡 THE ULTIMATE SET FOR BEGINNERS: The natural soy wax candle making kit comes in a beautiful giftable box and has lots o…
- 💛 A GREAT ACTIVITY FOR THE FAMILY: What better way to enjoy some creative DIY time with your family than by making scent…
- 💚 YOU DON’T HAVE TO BE AN EXPERT CANDLE MAKER TO MAKE STUNNING CANDLES: Too many DIY craft kits end up causing confusion…
20. Create a Small-Scale Photo Album
Turn digital memories into a tactile treasure. A tiny photo album is the perfect quick project with big payoff.
Tips
- Print in a consistent size for a clean look
- Add captions with inside jokes or dates
Use it as a keepsake gift, desk accessory, or a personal time capsule.
21. Nature Walk Scavenger Journaling
Combine exploration with journaling for a mindful, refreshing hobby. A simple kit makes it easy to start anywhere.
What to Bring
- Notebook, pencil, small magnifier
- Camera or phone for quick notes
- Little bag for found treasures
End result: a log of sights, smells, and ideas that reframe your daily routine.
22. Build a Matchbox-Size Shelf Studio
Space-efficient craft studio crafted from a single shelf and clever storage. It’s productivity on a tiny footprint.
How to Assemble
- Plan a few compartments for tools
- Install small hooks for scissors and tapes
- Sand and paint for a finished look
Use it as your portable craft area—great for small apartments or busy weekends.
23. Ceramic Pinch Pots for Tiny Treasures
Hands-on clay meditation that yields cute, useful little bowls. No wheel required—perfect for beginners who want immediate results.
Process
- Roll clay into a ball, pinch and smooth the walls
- Shape the rim and base for stability
- Glaze and fire if available, or seal paint for display only
Practical, charming, and perfect for holding jewelry, rings, or desk odds and ends.
24. DIY Cardboard Sculpture Challenge
Turn plain cardboard into a statement piece. It’s surprisingly doable with basic tools and a lot of imagination.
What to Create
- A geometric cage, a quirky animal, or a whimsical tower
- Use glue, tape, and a little paint to finish
Benefits: an affordable way to flex creative problem-solving and maybe impress your own inner kid.
25. Create a Personal Tarot or Oracle Deck

A mindful, creative project that doubles as daily guidance. Design your own imagery and meanings for a deck that truly reflects you.
Getting Started
- Sketch card faces with a cohesive color scheme
- Write brief meanings that resonate with you
- Print or hand-paint the backs for a finished look
End result: a one-of-a-kind deck you can shuffle while you sip tea and daydream about your next move.
Ready to pick a few and start today? When it comes to hobbies and crafts, the best one is the one you actually finish — so choose something that excites you enough to pick up again tomorrow.
Whatever you choose, you’ll gain momentum, new skills, and a pocketful of proud moments. Trust me, trying these will turn stuck days into spark-filled ones.









